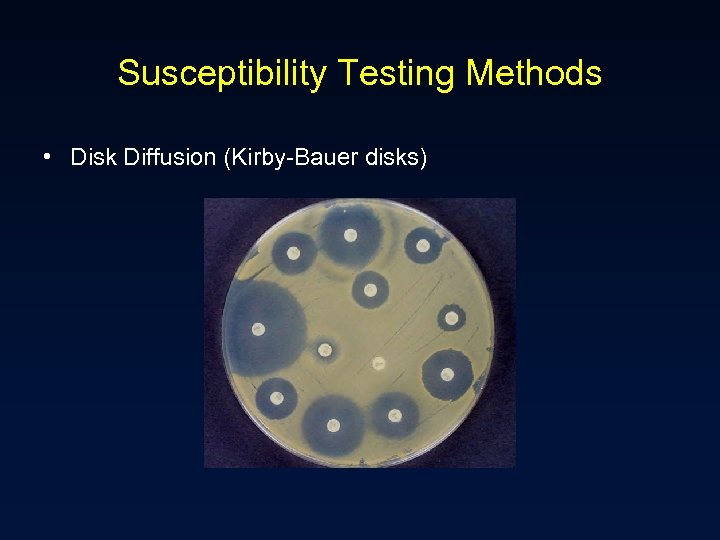
Susceptibility Testing Methods • Disk Diffusion (Kirby-Bauer disks)

d7721bbfe55be6462d31c3ef31dda89b.ppt
- Количество слайдов: 51

Introduction to Antimicrobial Therapy Christine Kubin, Pharm. D. , BCPS Clinical Pharmacist, Infectious Diseases New York-Presbyterian Hospital-CUMC October 22, 2004

Objectives • Review the classification of antimicrobials • Define pharmacokinetic and pharmacodynamic principles and their relationship to effective antimicrobial therapy • Review relevant microbiologic information as it relates to choosing an antimicrobial • Discuss patient and drug related factors that influence the selection of the appropriate antimicrobial agent • Identify monitoring parameters to evaluate antimicrobial therapy

What are Antimicrobials? ? ? • Antimicrobials are drugs that destroy microbes, prevent their multiplication or growth, or prevent their pathogenic action – Differ in their physical, chemical, and pharmacological properties – Differ in antibacterial spectrum of activity – Differ in their mechanism of action

Classification of Antimicrobials • Inhibit cell wall synthesis – – – • Penicillins Cephalosporins Carbapenems Monobactams (aztreonam) Vancomycin Inhibit protein synthesis – – – Chloramphenicol Tetracyclines Macrolides Clindamycin Streptogramins (quinupristin/dalfopristin) – Oxazolidinones (linezolid) – Aminoglycosides • Alter nucleic acid metabolism – Rifamycins – Quinolones • Inhibit folate metabolism – Trimethoprim – Sulfamethoxazole • Miscellaneous – Metronidazole – Daptomycin

Case Presentation #1 • S. I. is a 72 y. o. male with history of SAH s/p aneurysm clipping about 2 months ago. His post-op course was complicated by ventilatorassociated pneumonia, hydrocephalus requiring a VP shunt, and renal failure. Now admitted with acute mental status changes and fever. • • • PMH: SAH, DM, HTN, hypercholesterolemia FH: non-contributory SH: +tobacco (4 cigarettes/day) Allergies: NKDA Occupation: attorney

Case Presentation #1 • PE: – T 102. 7°F, – Tachycardic • Labs: – – – WBC 14. 7, Hct 34. 3, plts 295 Na 138, K 4. 1, Cl 102, HCO 3 25, BUN 26, SCr 1. 4 LFTs wnl Cultures pending CSF: WBC 725 (96% neutrophils); protein 148; glucose 39 • Diagnosis: VP shunt infection • Treatment: Antibiotics and shunt removal – Antibiotics? – Route? – Dose?

Case Presentation #2 • 43 y. o. male with congenital bladder extrophy (s/p multiple surgeries now with ureterocolostomy and colostomy), residual short bowel syndrome, multiple hospital admisisons for UTIs, sepsis, recently admitted for 1 month with polymicrobial line sepsis, line removed, PICC placed. Returns 10 days later complaining of abdominal pain, N/V. • • PMH: HTN FH: non-contributory SH: no tobacco, occasional alcohol use Allergies: PCN

Case Presentation #2 • PE: – T 99. 7°F – Lungs clear – Abdomen soft, but indurated area below urostomy bag • Labs: – – WBC 12. 4 ( from 7. 1), Hct 34. 8, Plts 290 Na 139, K 3. 7, Cl 105, HCO 3 20, BUN 40, SCr 1. 8 LFTs wnl U/A: 20 WBCs • CT scan: – Abdominal: cystic mass in pelvis with new hydronephrosis • 4 days into hospital admission, the cystic collection spontaneously drains. Patient febrile to 101. 7°F, tachycardic, increased WBC to 26. 4. Cultures drawn. Started on broad spectrum antibiotics.

Selecting an Antimicrobial • Confirm the presence of infection – History and physical – Signs and symptoms – Predisposing factors • Identification of pathogen – – Collection of infected material Stains Serologies Culture and sensitivity • Selection of presumptive therapy – Drug factors – Host factors • Monitor therapeutic response – Clinical assessment – Lab tests – Assessment of therapeutic failure

Antimicrobial therapy • Empiric – Infecting organism(s) not yet identified – More “broad spectrum” • Definitive – Organism(s) identified and specific therapy chosen – More “narrow” spectrum • Prophylactic or preventative – Prevent an initial infection or its recurrence after infection

Selecting an Antimicrobial • Confirm the presence of infection – History and physical – Signs and symptoms – Predisposing factors • Identification of pathogen – – Collection of infected material Stains Serologies Culture and sensitivity • Selection of presumptive therapy – Drug factors – Host factors • Monitor therapeutic response – Clinical assessment – Lab tests – Assessment of therapeutic failure

Is the Patient Infected? ? ? • CAREFUL history and physical exam including relevant laboratory data and signs and symptoms – Temperature – White blood cell count (WBC) » WBC in normally sterile fluids (e. g. CSF) – Any swelling or erythema at a particular site – Purulent drainage from a visible site – Patient complaints • Predisposing factors – Surgery, procedures, physical limitations, etc.

Selecting an Antimicrobial • Confirm the presence of infection – History and physical – Signs and symptoms – Predisposing factors • Identification of pathogen – – Collection of infected material Stains Serologies Culture and sensitivity • Selection of presumptive therapy – Drug factors – Host factors • Monitor therapeutic response – Clinical assessment – Lab tests – Assessment of therapeutic failure

Culture Results • Minimum inhibitory concentration (MIC) – The lowest concentration of drug that prevents visible bacterial growth after 24 hours of incubation in a specified growth medium – Organism and antimicrobial specific – Interpretation » » Pharmacokinetics of the drug in humans Drug’s activity versus the organism Site of infection Drug resistance mechanisms • Report organism(s) and susceptibilities to antimicrobials – Susceptible (S) – Intermediate (I) – Resistant (R)

Culture Results Example

Culture Results Example
Susceptibility Testing Methods • Disk Diffusion (Kirby-Bauer disks)

Susceptibility Testing Methods • Broth Dilution

Susceptibility Testing Methods • E-test (epsilometer test)

Selecting an Antimicrobial • Confirm the presence of infection – History and physical – Signs and symptoms – Predisposing factors • Identification of pathogen – – Collection of infected material Stains Serologies Culture and sensitivity • Selection of presumptive therapy – Drug factors – Host factors • Monitor therapeutic response – Clinical assessment – Lab tests – Assessment of therapeutic failure

Drug Factors

Pharmacokinetics • Absorption – IM, SC, topical – GI via oral, tube, or rectal administration – Bioavailability = amount of drug that reaches the systemic circulation • Distribution – Affected by the drug’s lipophilicity, partition coefficient, blood flow to tissues, p. H, and protein binding • Metabolism – Phase I » Generally inactivate the substrate into a more polar compound » Dealkylation, hydroxylation, oxidation, deamination » Cytochrome P-450 system (CYP 3 A 4, CYP 2 D 6, CYP 2 C 9, CYP 1 A 2, CYP 2 E 1) – Phase II » Conjugation of the parent compound with larger molecules, increasing the polarity » Generally inactivate the parent compound » Glucuronidation, sulfation, acetylation

Pharmacokinetics • Elimination – Total body clearance » Renal + non-renal clearance » Affects half-life (t 1/2) – Renal clearance » Glomerular filtration, tubular secretion, passive diffusion » Dialysis – Non-renal clearance » Sum of clearance pathways not involving the kidneys » Usually hepatic clearance, but also via biliary tree, intestines, skin – Half-life » Steady state concentrations reached after 4 -5 half lives » Varies from patient to patient » Affected by changes in end-organ function and protein binding

Pharmacodynamics • Attempts to relate drug concentrations to their effect in the body – Desirable = bacterial killing – Undesirable = drug side effects • Bacteriostatic – Inhibit growth or replication • Bactericidal – Cause cell death

Pharmacokinetics, Pharmacodynamics, and the MIC • Concentration vs. time-dependent killing agents – Concentration dependent agents bacterial killing as the drug concentrations exceed the MIC » Peak/MIC (AUC/MIC) ratio important » Quinolones, aminoglycosides – Time-dependent agents kill bacteria when the drug concentrations exceed the MIC » Time>MIC important » Penicillins, cephalosporins • Post antibiotic effect (PAE) – Delayed regrowth of bacteria following exposure to the antimicrobial » Varies according to drug-bug combination

Concentration-dependent and Timedependent agents vs. Pseudomonas aeruginosa

AUC/MIC and Survival Relationship for Quinolones JID 1989: 159: 281 -2.

AUC/MIC and Outcomes Relationship for Ciprofloxacin AAC 1993; 37: 1073 -81.

Pharmacodynamic Parameters and Colony Count after 24 hours for Cefotaxime in K. pneumoniae Diagn Microbiol Infect Dis 1995; 22: 89 -96

Antimicrobial Pharmacodynamic Parameters Antimicrobials Pharmacodynamic Characteristics Goal of Regimen Parameter Correlating with In Vivo Efficacy Aminoglycosides Quinolones Metronidazole Daptomycin Concentrationdependent Killing and Prolonged Persistent Effects Maximization of Concentrations Peak/MIC AUC 0 -24/MIC Penicillins Cephalosporins Aztreonam Time-dependent Killing and NO Persistent Effects Maximization of Exposure Time Serum Levels Exceed MIC/MBC Carbapenems Vancomycin Clindamycin Macrolides Time-dependent Killing and Prolonged Persistent Effects Maximization of Exposure Time Serum Levels Exceed MIC/MBC (serum levels can fall below the MIC)

Post Antibiotic Effect (PAE) • Delayed regrowth of bacteria following exposure to an antibiotic – Varies according to drug-bug combination • Gram-positive organisms – Most antibiotics (beta-lactams) exhibit PAE ~1 -2 hours – Aminoglycosides exhibit PAE < 1 hour • Gram-negative organisms – Most beta-lactams (except imipenem) have a negligible PAE – Aminoglycosides and quinolones have PAE > 2 hours • Clinical significance unknown – Helps choose appropriate dosing interval

Aminoglycoside Concentrations 1. 7 mg/kg q 8 h dosing

Aminoglycoside Concentrations 5 mg/kg q 24 h dosing

Other Drug Factors • Adverse effect profile and potential toxicity • Cost – – Acquisition cost + storage + preparation + distribution + administration Monitoring Length of hospitalization + readmissions Patient quality of life • Resistance – Effects of the drug on the potential for the development of resistant bacteria in the patient, on the ward, and throughout the institution

Host Factors • Allergy – Can be severe and life threatening – Previous allergic reaction most reliable factor for development of a subsequent allergic reaction – Obtain thorough allergy history – Penicillin allergy » Avoid penicillins, cephalosporins, and carbapenems in patients with true anaphylaxis, bronchospasm » Potential to use cephalosporins in patients with a history of rash (~5 -10% cross reactivity) • Age – May assist in predicting likely pathogens and guide empiric therapy – Renal and hepatic function vary with age » Neonates and elderly

Host Factors • Pregnancy – Fetus at risk of drug teratogenicity » All antimicrobials cross the placenta in varying degrees » Penicillins, cephalosporins, erythromycin appear safe – Altered drug disposition » Penicillins, cephalosporins, and aminoglycosides are cleared more rapidly during pregnancy » intravascular volume, glomerular filtration rate, hepatic and metabolic activities • Genetic or metabolic abnormalities – Glucose-6 -phosphate dehydrogenase (G 6 PD) deficiency • Renal and hepatic function – Accumulation of drug metabolized and/or excreted by these routes with impaired function – risk of drug toxicity unless doses adjusted accordingly – Renal excretion is the most important route of elimination for the majority of antimicrobials • Underlying disease states – Predispose to particular infectious diseases or alter most likely organisms

Site of Infection • Most important factor to consider in antimicrobial selection • Defines the most likely organisms – Especially helpful in empiric antimicrobial selection • Determines the dose and route of administration of antimicrobial – Efficacy determined by adequate concentrations of antimicrobial at site of infection – Serum concentrations vs. tissue concentrations and relationship to MIC


Site of Infection Will the antibiotic get there? • Choice of agent, dose, and route important – Oral vs. IV administration » Bioavailability, severity of infection, site of infection, function of GI tract – Blood and tissue concentrations » Ampicillin/piperacillin concentrations in bile » Fluoroquinolones concentrations in bone » Quinolones, TMP/SMX, cephalosporins, amoxicillin concentrations in prostate – Ability to cross blood-brain barrier » Dependent on inflammation, lipophilicity, low mw, low protein binding, low degree of ionization » 3 rd or 4 th generation cephalosporins, chloramphenicol, ampicillin, PCN, oxacillin – Local infection problems » Aminoglycosides inactivated by low p. H and low oxygen tension » Beta-lactams inoculum effect

Concomitant Drug Therapy • Influences the selection of appropriate drug therapy, the dosage, and necessary monitoring • Drug interactions – risk of toxicity or potential for efficacy of antimicrobial – May affect the patient and/or the organisms – Pharmacokinetic interactions » Alter drug absorption, distribution, metabolism, or excretion – Pharmacodynamic interactions » Alter pharmacologic response of a drug » Selection of combination antimicrobial therapy ( 2 agents) requires understanding of the interaction potential

Drug Interactions • Pharmacokinetic – An alteration in one or more of the object drug’s basic parameters • Absorption – Bioavailability • Distribution – Protein binding • Metabolism – CYP 450 • Elimination – renal • Pharmacodynamic – An alteration in the drug’s desired effects • Synergistic/additive – May lead to desired or toxic effect • Antagonistic – May lead to detrimental effects • Indirect effects – Effect of one drug alters effect of another

Combination Antimicrobial Therapy • Synergistic • Antagonistic • Indifferent

Selecting an Antimicrobial • Confirm the presence of infection – History and physical – Signs and symptoms – Predisposing factors • Identification of pathogen – – Collection of infected material Stains Serologies Culture and sensitivity • Selection of presumptive therapy – Drug factors – Host factors • Monitor therapeutic response – Clinical assessment – Lab tests – Assessment of therapeutic failure

Monitoring • Efficacy and toxicity of antimicrobials • Clinical assessment – Improvement in signs and symptoms » Fever curve, WBC » erythema, pain, cough, drainage, etc. • Antimicrobial regimen – – Serum levels Renal and/or hepatic function Other lab tests as needed Consider IV to PO switch • Microbiology reports – Modify antimicrobial regimen to susceptibility results if necessary » Resistance? – “Narrow” spectrum of antimicrobial if appropriate

Antimicrobial Factors in Drug Selection

Case Presentation #1 • Factors to consider: – Site of infection (likely organisms gram positive and gram negative) » Recently hospitalized » Neurosurgery – Antibiotic penetration into CSF » Route of administration – Age – Renal function • Patient empirically started on vancomycin 1 gram IV Q 24 h and cefepime 2 grams IV Q 12 h.

Cultures grew…. Cultures grew MSSA, patient’s therapy changed to oxacillin + rifampin. Shunt removed. WBC . Patient completed course of IV antibiotics. Monitor for resolution of infection Monitor hepatic profile

Case Presentation #2 • Factors to consider: – – Most likely abdominal source (gram negative and anaerobic organisms) PCN allergy Renal/hepatic function Multiple admissions and multiple infections » ? resistant organisms – IV vs. PO antibiotics » Short bowel syndrome • Patient received empiric levofloxacin 500 mg IV Q 24 h, metronidazole 500 mg IV Q 12 h, and vancomycin 1 g IV Q 24 h.

Cultures grew…. Levofloxacin and metronidazole continued to complete a course of therapy. Surgical intervention. Vancomycin discontinued.

Summary • Antimicrobials are essential components to treating infections • Appropriate selection of antimicrobials is more complicated than matching a drug to a bug • While a number of antimicrobials potentially can be considered, clinical efficacy, adverse effect profile, pharmacokinetic disposition, and cost ultimately guide therapy • Once an agent has been chosen, the dosage must be based upon the size of the patient, site of infection, route of elimination, and other factors • Optimize therapy for each patient and try to avoid patient harm • Use antimicrobials only when needed for as short a time period as needed to treat the infection in order to limit the emergence of bacterial resistance

QUESTIONS?
d7721bbfe55be6462d31c3ef31dda89b.ppt